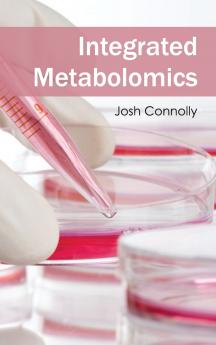
Integrated Metabolomics

English
Hardback
₹14017
₹16052
12.68% OFF
(All inclusive*)
Delivery Options
Please enter pincode to check delivery time.
*COD & Shipping Charges may apply on certain items.
Review final details at checkout.
Looking to place a bulk order? SUBMIT DETAILS
About The Book
Description
Author
This book is a well-structured resource for a comprehensive understanding of metabolomics. It is a speedily rising field in life sciences which plans to recognize and enumerate metabolites in a natural system. Methodical chemistry is combined with complicated informatics and information tools to establish and comprehend metabolic modification upon ecological perturbations. Jointly with added omics study such as genomics and proteomics metabolomics plays a significant part in practical genomics. This book will offer the reader complete modern knowledge and techniques particularly in the data examination approaches. It even deals with functions of metabolomics in human physical condition research protection assessments and plant research.
Delivery Options
Please enter pincode to check delivery time.
*COD & Shipping Charges may apply on certain items.
Review final details at checkout.
Details
ISBN 13
9781632394309
Publication Date
-27-03-2015
Pages
-380
Weight
-602 grams
Dimensions
-152x229x22.23 mm